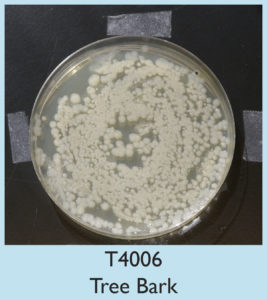

- About
- People
- Research
- Education
- News & Events
- Marine Operations
- Resources
- Housing
- Meeting Spaces
- Speakers Bureau
- ——————–
- Microbial Imaging Lab
- Raman Microscope Facility
- Stable Isotope Laboratory
- ——————–
- Georgia Coastal Hazards Portal
- Weather Station
- Sea Level Sensor
- Skidaway Island Seismograph
- ——————–
- Microplastics Links and Information
- Sea Level Rise Links
- Resources for Teachers & Students
- International Workshop on Western Boundary Current – Subtropical Continental Shelf Interactions
- Blogs
- Support UGA Skidaway Inst.
- Contact Us
- About
- People
- Research
- Education
- News & Events
- Marine Operations
- Resources
- Housing
- Meeting Spaces
- Speakers Bureau
- ——————–
- Microbial Imaging Lab
- Raman Microscope Facility
- Stable Isotope Laboratory
- ——————–
- Georgia Coastal Hazards Portal
- Weather Station
- Sea Level Sensor
- Skidaway Island Seismograph
- ——————–
- Microplastics Links and Information
- Sea Level Rise Links
- Resources for Teachers & Students
- International Workshop on Western Boundary Current – Subtropical Continental Shelf Interactions
- Blogs
- Support UGA Skidaway Inst.
- Contact Us